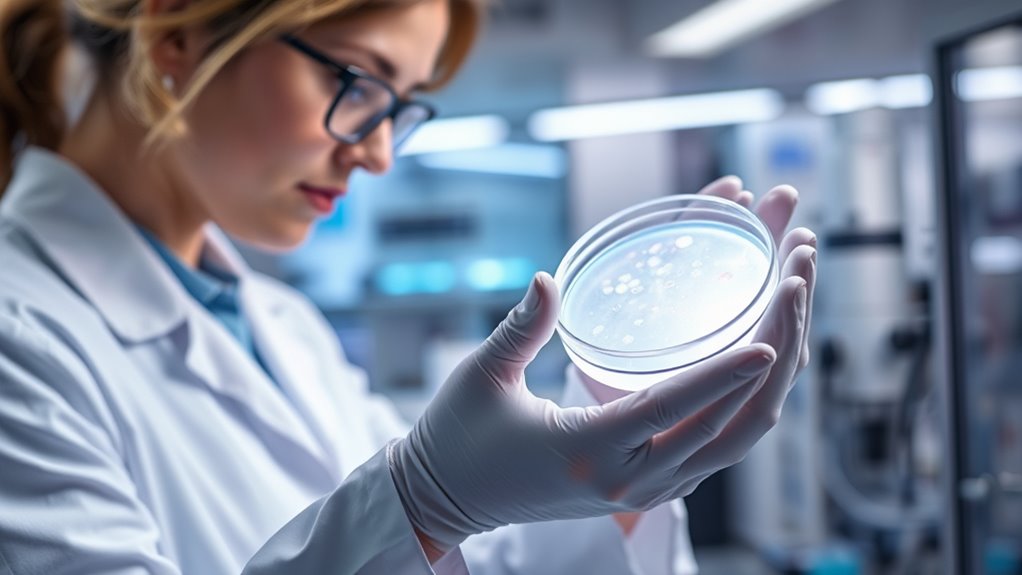
hormonelle Behandlung zur Fruchtbarkeitssteigerung
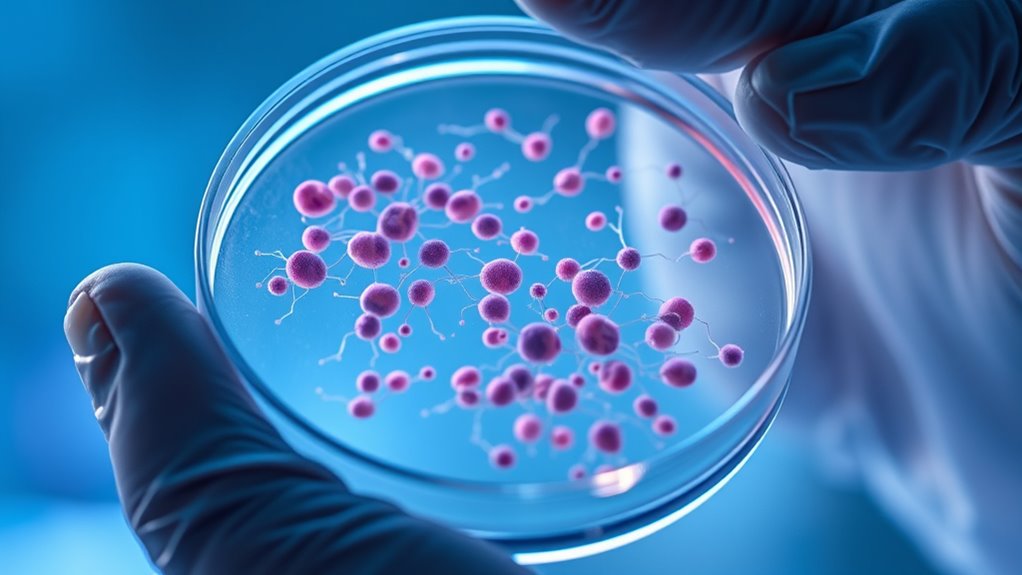
Überwachung von Resistenz und Behandlung

Antihormonelle Therapie behandelt hormonabhängige Tumoren, indem sie Hormonspiegel senkt oder blockiert, die das Krebswachstum antreiben. Man könnte Medikamente wie Tamoxifen oder Aromatasehemmer bei Brustkrebs verwenden oder eine Androgensuppressionstherapie bei Prostatakrebs. Diese Behandlungen verhindern, dass Hormone die Tumorrezeptoren aktivieren, was das Fortschreiten verlangsamt oder stoppt. Resistenzmanagement und die Überwachung des Therapieerfolgs sind wesentliche Bestandteile der Behandlung. Wenn Sie weiter forschen, werden Sie mehr darüber erfahren, wie diese Strategien funktionieren und in welchen spezifischen Fällen sie angewendet werden.
Wichtigste Erkenntnisse
- Antihormonelle Therapie blockiert Hormone oder deren Rezeptoren, um das Wachstum hormonabhängiger Tumoren wie Brust- und Prostatakrebs zu hemmen.
- Gängige Wirkstoffe sind Tamoxifen, Aromatasehemmer und Fulvestrant bei Brustkrebs sowie LHRH-Analoga plus Antiandrogene bei Prostatakrebs.
- Ziel der Behandlung ist es, das Tumorwachstum, Rückfälle zu verhindern und die Überlebensrate zu verbessern, indem hormongetriebene Signale reduziert werden.
- Die Überwachung umfasst Bildgebung und Biomarker, wobei Kombinationstherapien eingesetzt werden, um Resistenzen zu überwinden und die Wirksamkeit zu verlängern.
- Hormonelle Therapien können auch zur Fertilitätserhaltung und bei der Behandlung von Endometriumtumoren angewendet werden, wenn eine Operation nicht möglich ist.
Tamoxifen Medikamente für Brustkrebs
As an affiliate, we earn on qualifying purchases.
As an affiliate, we earn on qualifying purchases.
Überblick über antihormonelle Therapie und ihre Wirkmechanismen

Haben Sie sich jemals gefragt, wie die Manipulation von Hormonen bei der Behandlung bestimmter Krebsarten helfen kann? Antihormonelle Therapie funktioniert, indem sie Hormonspiegel verändert oder deren Wirkung auf Krebszellen blockiert. Sie wird hauptsächlich bei Tumoren eingesetzt, die auf Hormone wie Östrogen, Progesteron oder Androgene angewiesen sind. Diese Therapie verhindert, dass Hormone sich an ihre Rezeptoren auf den Krebszellen binden, was das Tumorwachstum verlangsamt oder stoppt. Gängige Medikamente sind Tamoxifen, Aromatasehemmer und Androgenentzugstherapien. Diese Medikamente zielen auf bestimmte Hormonrezeptoren ab, um die Signale zu reduzieren, die das Wachstum der Krebszellen fördern. Das Ziel ist, das Fortschreiten oder Wiederauftreten des Krebses zu verhindern und die Überlebenschancen der Patienten zu verbessern. Durch Eingriffe in die Hormon-Signalwege bietet die antihormonelle Therapie einen zielgerichteten Ansatz, der Schäden an gesunden Geweben minimiert und sie somit zu einer effektiven Option für hormonabhängige Krebsarten macht.
Aromatasehemmer für hormonabhängigen Brustkrebs
As an affiliate, we earn on qualifying purchases.
As an affiliate, we earn on qualifying purchases.
Strategien zur Behandlung von Brustkrebs mit Hormontherapien

Die Behandlung von Brustkrebs mit hormonellen Therapien umfasst die Auswahl der geeigneten Therapie basierend auf dem Rezeptorstatus des Tumors, dem Stadium und der Gesundheit des Patienten. Wenn Ihr Tumor Östrogen- oder Progesteronrezeptor-positiv ist, sind Optionen wie Tamoxifen häufig die Erstlinientherapie, insbesondere bei frühzeitigem Krankheitsstadium. Bei postmenopausalen Frauen werden Aromatasehemmer wie Anastrozol, Letrozol oder Exemestane in der Regel bevorzugt, um das Rückfallrisiko zu senken, wenn sie als adjuvante Therapie eingesetzt werden. Für fortgeschrittene oder metastatische Fälle helfen Medikamente wie Fulvestrant oder Toremifene, das Tumorwachstum zu kontrollieren. Es ist wichtig, den Behandlungsverlauf regelmäßig durch Bildgebung und klinische Bewertungen zu überwachen. Die Kombination verschiedener hormoneller Wirkstoffe oder die Hinzufügung zielgerichteter Therapien kann die Resistance verzögern und die Behandlungsergebnisse verbessern. Ihr medizinisches Team wird die Strategie anpassen, um Vorteile zu maximieren, Nebenwirkungen zu minimieren und die Lebensqualität aufrechtzuerhalten.
LHRH-Analoga bei Prostatakrebs
As an affiliate, we earn on qualifying purchases.
As an affiliate, we earn on qualifying purchases.
Ansätze zur Behandlung von Prostatakrebs unter Verwendung von Androgensuppression

Androgenunterdrückung bleibt die Grundpfeiler der Behandlung von Prostatakrebs, insbesondere in fortgeschrittenen Stadien. Dies kann durch chirurgische Kastration (Orchiektomie) oder medikamentöse Kastration mit Luteinisierungshormon-freisetzendem Hormon (LHRH)-Agonisten oder -Antagonisten erreicht werden. Diese Therapien reduzieren Testosteronspiegel, die das Tumorwachstum antreiben. Die Kombination von Hormonentzugstherapie (ADT) mit neueren Wirkstoffen wie Enzalutamid oder Abirateron erhöht die Wirksamkeit, insbesondere bei metastasiertem Krankheitsverlauf. Falls der Krebs kastrationsresistent wird, können sekundäre hormonelle Therapien in Betracht gezogen werden, die Medikamente umfassen, die die Androgenrezeptorwege angreifen oder die Androgensynthese hemmen. Regelmäßige Überwachung der Testosteronwerte und Bildgebung helfen, den Behandlungserfolg zu bewerten. Seien Sie sich bewusst, dass Nebenwirkungen wie Hitzewallungen, verringerte Libido, Osteoporose und Müdigkeit Ihre Lebensqualität beeinträchtigen können, weshalb eine sorgfältige Behandlung notwendig ist. Der Einsatz von for sale 100-Optionen für unterstützende Behandlung oder Pflege kann ebenfalls die Patientenergebnisse und das Wohlbefinden verbessern.
Hormontherapie Überwachungstests
As an affiliate, we earn on qualifying purchases.
As an affiliate, we earn on qualifying purchases.
Hormonelle Therapeutika bei Endometriumkarzinom und Fruchtbarkeitserhaltung
In Fällen, in denen eine Operation keine Option ist oder wenn Fruchtbarkeitserhaltung Priorität hat, bieten hormonelle Therapien eine wertvolle Alternative zur Behandlung von Endometriumkarzinomen. Sie können Progestine wie Medroxyprogesteronacetat oder Megestrolacetat in Betracht ziehen, die auf hormonrezeptorpositive Tumoren abzielen. Diese Behandlungen können eine Tumorrückbildung bewirken und Frauen die Erhaltung der Fruchtbarkeit ermöglichen. Intrauterine Geräte, die Progestine freisetzen, bieten eine lokalisierte Therapie mit weniger systemischen Nebenwirkungen. Aromatase-Hemmer könnten ebenfalls verwendet werden, insbesondere bei postmenopausalen Frauen, um den Östrogenspiegel zu senken und das Tumorwachstum zu hemmen. Obwohl die Evidenz im Vergleich zu Brust- oder Prostatakrebs begrenzt ist, können hormonelle Therapien bei frühzeitigem Stadium wirksam sein. Regelmäßige Überwachung durch klinische Untersuchungen und bildgebende Verfahren ist unerlässlich, um die Reaktion zu beurteilen und Rückfälle frühzeitig zu erkennen, um die sichere Fruchtbarkeitserhaltung zu gewährleisten.
Umgang mit Widerstand und Überwachung bei Behandlungen von hormonabhängigen Tumoren
Widerstand gegen hormonelle Therapien stellt eine bedeutende Herausforderung bei der Behandlung hormonabhängiger Tumoren dar und führt oft trotz anfänglicher Reaktionen zum Fortschreiten der Erkrankung. Um dies zu adressieren, müssen Sie die Wirksamkeit der Behandlung regelmäßig durch Bildgebung und Biomarker-Bewertungen überwachen. Die Verfolgung von Tumormarkern wie CA 15-3 oder PSA hilft, frühe Anzeichen von Resistenz zu erkennen. Wenn Widerstand auftritt, kann eine Kombinationstherapie, die verschiedene Wege angreift, wie z.B. PI3K/AKT/mTOR-Inhibitoren, die Empfindlichkeit wiederherstellen. Sie sollten auch den Wechsel oder die Ergänzung von Medikamenten wie Fulvestrant oder Abirateron in Betracht ziehen, um Resistenzmechanismen zu überwinden. Eine kontinuierliche Bewertung der Nebenwirkungen und der Lebensqualität des Patienten bleibt unerlässlich. Darüber hinaus kann das Verständnis der Rolle elterlichen Einflusses bei der Patientenbetreuung dazu beitragen, die Therapietreue zu verbessern und emotionale Unterstützung während der Behandlung zu gewährleisten. Durch aktive Überwachung und Anpassung der Behandlungspläne können Sie die Ergebnisse verbessern und das Fortschreiten verzögern, sodass die Therapie länger wirksam bleibt und das Wohlbefinden des Patienten erhalten wird.
Häufig gestellte Fragen
Was sind die neuesten Entwicklungen bei antihormonellen Therapien?
Sie sollten wissen, dass aktuelle Fortschritte neue zielgerichtete Wirkstoffe umfassen, wie CDK 4/6-Inhibitoren bei Brustkrebs, die die Ergebnisse in Kombination mit hormoneller Therapie verbessern. Beim Prostatakrebs bieten neuartige Androgenrezeptor-Antagonisten, wie Enzalutamid, eine bessere Wirksamkeit bei resistenten Fällen. Zusätzlich zeigen Kombinationstherapien, die auf Wege wie PI3K/AKT/mTOR abzielen, vielversprechende Ergebnisse, und personalisierte Ansätze mit genetischer Profilierung lenken die Behandlungsentscheidungen, um die Wirksamkeit zu erhöhen und Resistenzen zu verringern.
Wie unterscheiden sich die Nebenwirkungen bei verschiedenen antihormonellen Medikamenten?
Sie könnten überrascht sein, wie Nebenwirkungen bei antihormonellen Medikamenten variieren. Zum Beispiel kann Tamoxifen das Risiko für Blutgerinnsel und Gebärmutterschleimhautprobleme erhöhen, während Aromatasehemmer häufig Gelenkschmerzen und Osteoporose verursachen. Androgenentzugstherapie kann Hitzewallungen, Müdigkeit und Stoffwechselveränderungen zur Folge haben. Das individuelle Nebenwirkungsprofil jedes Medikaments beeinflusst Ihre Behandlungswahl, daher ist es wichtig, diese Unterschiede zu kennen, um gemeinsam mit Ihrem Arzt bessere Entscheidungen zu treffen.
Kann antihormonelle Therapie mit zielgerichteten molekularen Therapien kombiniert werden?
Ja, Sie können hormonelle Therapien mit zielgerichteten molekularen Therapien kombinieren, um die Ergebnisse zu verbessern. Dieser Ansatz blockiert Hormonrezeptoren, während spezifische Wege wie PI3K/AKT/mTOR, die an der Resistenz beteiligt sind, angegriffen werden. Sie könnten Medikamente wie Everolimus zusammen mit hormonellen Mitteln einnehmen. Die Kombination dieser Behandlungen kann Resistenz verzögern, die Wirksamkeit erhöhen und die Therapie personalisieren. Seien Sie sich jedoch bewusst, dass dies die Nebenwirkungen erhöhen kann. Daher sind Überwachung und Management der Toxizität für optimale Ergebnisse unerlässlich.
Was ist die Auswirkung einer antihormonellen Behandlung auf die langfristige Lebensqualität der Patienten?
Sie könnten denken, dass eine langfristige antihormonelle Behandlung ein Spaziergang im Park ist, aber sie ist oft mit einem hohen Preis für Ihre Lebensqualität verbunden. Nebenwirkungen wie Osteoporose, Hitzewallungen und Müdigkeit können den Alltag zur Herausforderung machen. Während sie Krebs effektiv bekämpft, fordert sie auch Opfer und erinnert Sie daran, dass das Retten Ihres Lebens manchmal bedeutet, auf einem schmalen Grat zwischen Behandlungsnutzen und täglichem Komfort zu balancieren.
Gibt es Biomarker, um die Resistenz gegen antihormonelle Therapien vorherzusagen?
Ja, mehrere Biomarker können dabei helfen, Resistenz gegen antihormonelle Therapien vorherzusagen. Sie sollten nach Mutationen im ESR1-Gen suchen, das die Estrogenrezeptoren kodiert, da diese häufig auf eine Resistenz bei Brustkrebs hinweisen. Zusätzlich können Veränderungen im PI3K/AKT/mTOR-Weg und eine Überexpression des HER2-Rezeptors ebenfalls auf eine potenzielle Resistenz hindeuten. Die Überwachung dieser Biomarker unterstützt Sie dabei, Behandlungen individuell anzupassen und Resistenz vorherzusehen, um die Behandlungsergebnisse für die Patienten zu verbessern.
Fazit
Sie könnten denken, dass hormonblockierende Therapien nur vorübergehend wirksam sind, aber mit richtigem Management und Überwachung können sie die Ergebnisse bei hormonabhängigen Tumoren erheblich verbessern. Durch das Verständnis der Mechanismen und die Anpassung der Behandlungen können Sie Resistenzprobleme frühzeitig erkennen und angehen, sodass Ihre Patienten langfristig profitieren. Lassen Sie sich nicht von Bedenken hinsichtlich der Resistenz abschrecken—fortlaufende Fortschritte bedeuten, dass Sie Strategien anpassen und die wirksame Kontrolle über diese Krebsarten aufrechterhalten können. Nutzen Sie diese Therapien für eine bessere Patientenversorgung und Hoffnung.